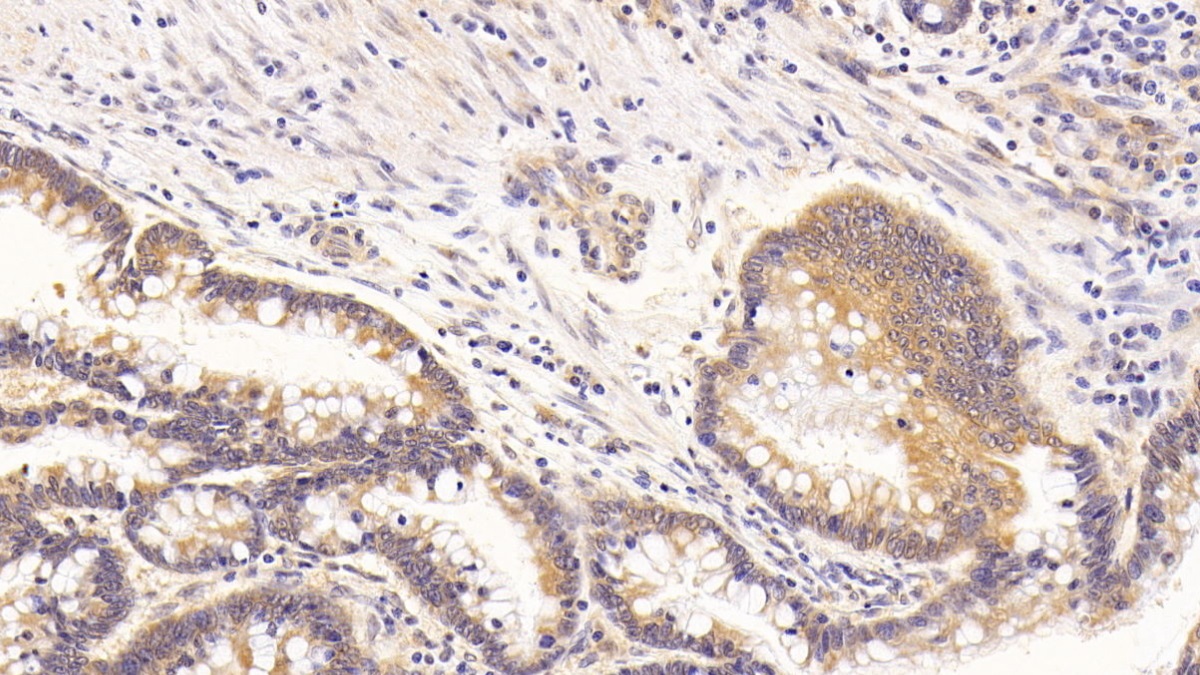

Monoclonal Antibody to Vascular Endothelial Growth Factor C (VEGFC)
VEGF-C; Flt4-L; VRPL; Vascular Endothelial Growth Factor-Related Protein
- Product No.MAA145Hu21
- Organism SpeciesHomo sapiens (Human) Same name, Different species.
- SourceMonoclonal antibody preparation
- HostMouse
- Potency (Clone Number)E2
- Ig Isotype IgG1 Kappa
- PurificationProtein A + Protein G affinity chromatography
- LabelNone
- Immunogen RPA145Hu01-Recombinant Vascular Endothelial Growth Factor C (VEGFC)
- Buffer Formulation0.01M PBS, pH7.4, containing 0.05% Proclin-300, 50% glycerol.
- TraitsLiquid
- Concentration1mg/mL
- Organism Species Moren/a
- ApplicationsIHC
If the antibody is used in flow cytometry, please check FCM antibodies. - DownloadInstruction Manual
- UOM 20µl100µl 200µl 1ml 10ml
- FOB
US$ 90
US$ 210
US$ 300
US$ 750
US$ 3000
For more details, please contact local distributors!
SPECIFITY
The antibody is a mouse monoclonal antibody raised against VEGFC. It has been selected for its ability to recognize VEGFC in immunohistochemical staining and western blotting.
USAGE
Western blotting: 0.5-2µg/mL
Immunohistochemistry: 5-20µg/mL
Immunocytochemistry: 5-20µg/mL
Optimal working dilutions must be determined by end user.
STORAGE
Store at 4°C for frequent use. Stored at -20°C in a manual defrost freezer for two year without detectable loss of activity. Avoid repeated freeze-thaw cycles.
STABILITY
The thermal stability is described by the loss rate. The loss rate was determined by accelerated thermal degradation test, that is, incubate the protein at 37°C for 48h, and no obvious degradation and precipitation were observed. The loss rate is less than 5% within the expiration date under appropriate storage condition.
GIVEAWAYS
INCREMENT SERVICES
-
 Antibody Labeling Customized Service
Antibody Labeling Customized Service
-
 Protein A/G Purification Column
Protein A/G Purification Column
-
 Staining Solution for Cells and Tissue
Staining Solution for Cells and Tissue
-
 Positive Control for Antibody
Positive Control for Antibody
-
 Tissue/Sections Customized Service
Tissue/Sections Customized Service
-
 Phosphorylated Antibody Customized Service
Phosphorylated Antibody Customized Service
-
 Western Blot (WB) Experiment Service
Western Blot (WB) Experiment Service
-
 Immunohistochemistry (IHC) Experiment Service
Immunohistochemistry (IHC) Experiment Service
-
 Immunocytochemistry (ICC) Experiment Service
Immunocytochemistry (ICC) Experiment Service
-
 Flow Cytometry (FCM) Experiment Service
Flow Cytometry (FCM) Experiment Service
-
 Immunoprecipitation (IP) Experiment Service
Immunoprecipitation (IP) Experiment Service
-
 Immunofluorescence (IF) Experiment Service
Immunofluorescence (IF) Experiment Service
-
 Buffer
Buffer
-
 DAB Chromogen Kit
DAB Chromogen Kit
-
 SABC Kit
SABC Kit
-
 Long-arm Biotin Labeling Kit
Long-arm Biotin Labeling Kit
-
 Real Time PCR Experimental Service
Real Time PCR Experimental Service
| Magazine | Citations |
| Journal of Cellular Biochemistry | Alternatively activated RAW264. 7 macrophages enhance tumor lymphangiogenesis in mouse lung adenocarcinoma PubMed: 19241443 |
| genetics and molecular research | Expression of COX-2 and VEGF-C in cholangiocarcinomas at different clinical and pathological stages PubMed: 26125824 |
| Experimental and Therapeutic | Fenofibrate inhibits the expression of VEGFC and VEGFR-3 in retinal pigmental epithelial cells exposed to hypoxia PubMed: 26622498 |
| Am J Pathol | IL-10 Indirectly Regulates Corneal Lymphangiogenesis and Resolution of Inflammation via Macrophages PubMed: 26608451 |
| PLoS One. | Interleukin-6 Induces Vascular Endothelial Growth Factor-C Expression via Src-FAK-STAT3 Signaling in Lymphatic Endothelial Cells. pubmed:27383632 |
| Oncology Letters | RNAi-mediated gene silencing of vascular endothelial growth factor C suppresses growth andinduces apoptosis in mouse breast cancer in vitro and in vivo. pubmed:27895746 |
| Angiogenesis | Characterization of isolated liver sinusoidal endothelial cells for liver bioengineering Pubmed:29582235 |
| Oncology Reports | Effects of diphyllin as a novel V-ATPase inhibitor on TE-1 and ECA-109 cells Pubmed:29328465 |
| LABORATORY INVESTIGATION | Dynamic signature of lymphangiogenesis during acute kidney injury and chronic kidney disease Pubmed: 31019289 |
| Cutaneous and Ocular Toxicology | Isotretinoin does not alter VEGF-A and VEGF-C levels: Do retinoids behave differently in dose-dependent and/or in vivo/in vitro conditions? Pubmed: 32722957 |